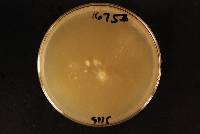

System maintenance is ongoing as of Monday, October 27, 2025. The portal is currently set to read only with no changes to content available at this time.
Please contact me at help@mycoportal.org if you have any questions.
Phlebia subfascicularis
|
|
|
|
Family: Meruliaceae
[Acia subfascicularis Wakef., more] |
|